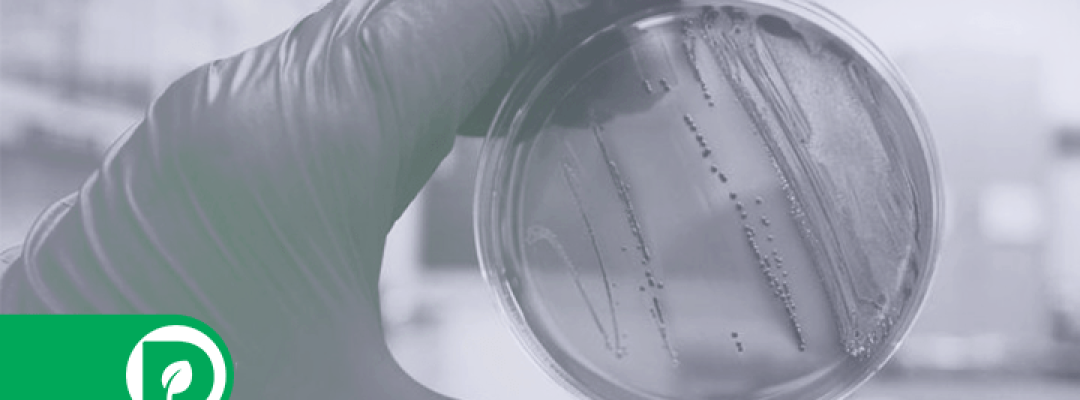

As doenças de veiculação hídrica, consideradas um sério problema de saúde pública, são originadas principalmente do contato com água contaminada com microrganismos causadores de doenças em animais e humanos. Em países em desenvolvimento, tanto adultos como crianças sofrem de doenças diarreicas infecciosas, sendo a água a principal fonte de exposição. Segundo a Organização Mundial da Saúde (OMS), todos os anos 361 mil crianças com menos de cinco anos, no mundo, morrem devido à diarreia provocada pela falta de saneamento básico e pela água contaminada.
As bactérias do grupo coliforme são frequentemente utilizadas para a avaliação da qualidade microbiológica da água, sendo que, desse grupo, a presença de Escherichia coli, uma bactéria termotolerante de origem exclusivamente fecal, possui uma grande importância clínica.
O Ministério da Saúde, por meio da Portaria GM/MS nº 888, 2021, recomenda que seja analisada a presença de coliformes totais e Escherichia coli para avaliar a qualidade microbiológica da água para consumo, e esses microrganismos devem estar ausentes na água consumida.
A PROMATEC em breve, realizará análises em água para determinar os ensaios de Coliformes Totais e Escherichia coli.
Referências:
World Health Organization (WHO), United Nations Children’s Fund (UNICEF). Progress on drinking water, sanitation and hygiene: 2017. Disponível em: https:// www.unicef.org/publications/index_96611. html#
Brasil. Portaria GM/MS nº 888, de 07 de maio de 2021. Dispõe sobre os procedimentos de controle e de vigilância da qualidade da água para consumo humano e seu padrão de potabilidade. Diário Oficial da República Federativa do Brasil, Brasília, DF, 07 mai. 2021.